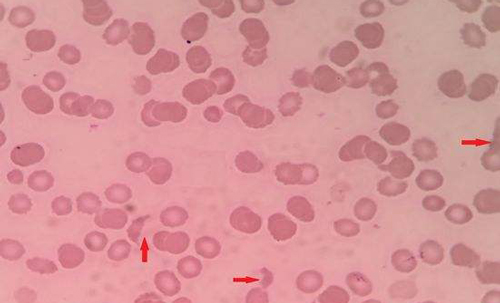
爱之晶海外试管名称解释——红细胞(RBC)
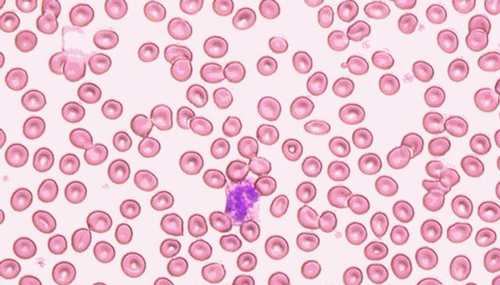
爱之晶海外试管名称解释——红细胞(RBC)

电话:19919999145
微信:17027022222
邮箱:kf@daiyun.cn
地址:国内、马来西亚、吉尔吉斯斯坦
发布时间:2021-11-18 点此:944次
什么是红细胞
红细胞在人类、动物身上都是能够看到的,在人体中红细胞担任着氧气的运送功能,同时会带着少许二氧化碳,并且在人体中还担任着一些免疫功能的媒介,在怀孕、助孕以及日常生活中如果红细胞出现异常,就应该尽早进行治疗。

红细胞是人体中担任氧气运输
中文名
直径
成分
英文缩写
颜色
主要功能
红细胞
7微米左右
血红蛋白
RBC
因数量众多常呈深红色
运输血液
人体红细胞一旦出现问题,那么就将会出现贫血,最后引发地中海贫血症;又或者发生最难以接受的血液疾病白血病,而这些病症的起因大多都红细胞异常导致,不管是大人、小孩还是孕妇都应该正确认识红细胞(BRC)。
红细胞检查
红细胞的检查,在医学上管用另外一种名称,那就是血液检查,而常用的红细胞检查方法为红细胞计数,在这种方式检查中将被分为两种红细胞检查方式,其中一种检查方式是常用检查方式,如果红细胞计数偏高原因,那么从红细胞计数中非常好了解。
红细胞检查方式
1、一种为已经快要放弃了的手工显微镜法,先将血液稀释到要求倍数后,在进行放入血细胞计数池中,在显微镜下实行计数,该法除了需要显微镜并不需要其他设备,但是操作相对来说非常复杂,以及费时;
2、另一中是常用的血液分析法,该法需要非常多的仪器,利用电阻抗以及光散射原理,即可的出红细胞计数结果,相对来说在很多医院以及替代了显微镜红细胞计数。
红细胞的检查方式分为手工显微镜检查以及血液分析检查
红细胞正常值
红细胞的正常值,是针对人体中每升血液的红细胞(BRC)数量,不管是偏高与正常值还是偏低与正常值,都会引发一些列的身体变化,而一旦出现了异常,医生都会建议患者首先检查出红细胞(BRC)偏离正常值原因。
男性与女性的红细胞正常值是有差距的,在与人对比的时候,两者之间不能够进行对比。
男性正常值
在成年正常男性中红细胞的正常值在4.0-5.5左右,以及血红蛋白在120-160左右,在这个正常值范围中皆属于正常。
女性正常值
成年女性红细胞正常值通常会在3.5-50之间,血红蛋白量通常在110-150左右,女性的红细胞(BRC)偏差可能会有点大,特别是在月经期的时候应注意。
Tips
红细胞正常值对于判断红细胞偏低、偏高是一个非常好的标准,在红细胞检查前应该禁烟禁酒,这样检查的数值才会变得更加的准确,而女性尽量避免月经期检查,因为这个时候的结果可能存在的差异,并且在平时的时候应该多喝水。
红细胞检查前应该多喝水,少运动这样检查结果才不会有太大偏差
红细胞偏高
红细胞偏高常常指的是患者经过血常规检查后确诊,红细胞体内的红细胞偏离正常值范围,出现红细胞高于正常值的现象,医生会根据其他检查意见红细胞偏高症状来确定红细胞偏高原因,并且进行对症指导治疗。
红细胞偏高原因
红细胞偏高引起的原因非常多,首先要知道红细胞偏高是什么病,有继发性红细胞偏高、相对性红细胞偏高以及原发性红细胞偏多,其中继发性与原发性红细胞偏高又被分为先天性问题以及后天性红细胞偏高。
不管是继发性、相对性或者原发性红细胞偏高,他们引起的原因都不相同,治疗调理方案也是不一样的,一些要从病症开始治疗,一些在家调理即可,所以确定红细胞偏高原因非常重要。

红细胞偏高病因有继发性、原发性、相对性3种
继发性红细胞偏高
继发性红细胞在通常情况并不会被称之为先天以及后天,在医学上常常被称之为继发病理性红细胞偏高,或者继发生理性红细胞偏高,其中它们的针对红细胞朴高原因并不一样。
01
生理性红细胞
生理上的红细胞偏高主要针对的是新生儿以及胎儿,它们在目前子宫中生产的时候可能就已经出现红细胞偏高,生理性的红细胞偏高主要引起原因是红细胞的自主生成过快过多。
生理性红细胞偏高原因
1、生理性红细胞偏高是什么引起,通常由环境缺氧或者其他特殊原因引起;
2、红细胞有点偏高较大可能是人体组织出现了缺氧;
3、生理性变化常见于胎儿、新生儿、长期处于缺氧环境中的人,常见高原地区。
病理性红细胞偏高:对于病理性红细胞偏高可以从字面意思上进行了解,那就是因为某种疾病的原因引起了红细胞偏高,呈现红细胞绝对值偏高,并有可能引起人体中的机体循环问题。
病理性红细胞偏高原因
1、常见红细胞偏高是什么原因造成的,多由肺部病症、青紫型先天性心脏病引起;
2、如人体组织没有出现缺氧那么很可能是由骨髓造血功能生成红血球,但是并不是身体要增加红血球。

生理性红细胞偏高主要是针对新生儿
02
原发性红细胞偏高
对于原发性红细胞偏高如果是先天造成,那么意味着胎儿体内的红细胞在某个时间段出现了基因突变的可能性;而相对于后天红细胞偏高常见于骨髓增多,或者是造血细胞直接出现了突变。
03
相对性红细胞偏高
对于相对性红细胞偏高来说,在医学领域上常是人体的血浆中容量等问题以及减少到超过警戒线了,并且导致红细胞相对性的增高,多见于甲状腺功能等原因,对于这种其实最好的就是孕期红细胞偏高怎么避免。
Tips
红细胞偏高是常见的一种红细胞问题,引起原因众多,但是因为其的治疗方式不同,所以在检查出红细胞偏高,并不能够立马进行治疗,而是先在医生的帮助下找出病因最后在进行针对治疗即可。

血浆容量一旦低过警戒线,将会出现相对性红细胞偏高
红细胞偏高危害
红细胞偏高的情况非常的多,但是多并不会有什么红细胞偏高危害,但是偏高数量非常大或者是继发于其他病症发生的,那么就需要在第一时间查明病因,然后进行针对性治疗,并在在治疗的同时加上食疗配合。
01
危害肺脏
不管是身体缺氧还是心脏跳动不足,都是会引起人体供氧不足的现象,而身体本能的想要供足送氧,就会出现红细胞猛然增高,来补全本来的缺陷,从而引发红细胞偏高危害。
长时间处于这种情况,那么将会引起其它并发症,并且红细胞偏高危害病情也会增重,尽早就医是最好的选择,明确红细胞偏高怎么办,这是对红细胞偏高有什么危害最好的解决办法。
02
危害缺氧肺气肿
缺氧状态肺气肿也常出现血细胞偏高症状之一,在血细胞偏高会怎么样中常常表达出缺氧性肺气肿,但是这种情况多发在高海拔、肺病患者在检查的时候可能会出现这种情况。
Tips
红细胞偏高如果只是因为在运动过后没有喝水就进行体检导致的(通常要避免),可以在后面进行复查,这种情况是不会身体造成影响及危害,但是如果是因为病症的原因引起,那么就需要立马进行病症治疗。

如是病理性红细胞偏高那么就应该从病症常开始治疗
红细胞偏高如何治疗
对于红细胞治疗中,要根据红细胞偏高的严重性在进行治疗,可能会出现各种并发症,为了防止出现最为严重的血液疾病所以在治疗中针对各阶段的红细胞偏高治疗,饮食治疗、放血治疗以及最为严重的需要化疗。
01
饮食运动
不管是在面对任何病症,清淡饮食是必须的,并且要多喝水保持人体有足够的水分,并且应少吃高脂肪饮食以及一些动物内脏,这是对于红细胞值偏高怎么办最好的治疗方式,并且完全没有任何副作用,并且运动也不能停下。
02
手术治疗
手术治疗是红细胞偏高解决办法之一,常采用放学的方式进行,对于放学治疗来说还是相对来说比较安全的方法,没有其它任何危害在其中,并且治疗周期是最短,也是最为方便的方式之一,也是作为红细胞偏高解决办法使用最多的方法。
03
化疗
化疗手术是治疗红细胞偏高中最不想接受的方式,但是对于太过于严重的红细胞偏高患者这是一个没有选择性方法,并且可以说是唯一有效的方式,所以对于还在纠结红细胞偏怎么办的患者应该听取医生的建议。
Tips
红细胞偏高治疗过程可能会较为漫长,在治疗中应该规范自身的作息时间、情绪等等,对于红细胞偏治疗是有非常大的帮助的,而相对来说只是偏高一点的,那么直接可以规范饮食、作息时间慢慢调理红细胞将会慢慢恢复正常。

在红细胞偏高化疗中可能会给患者带来一定的伤害
红细胞偏低
经检查发现红细胞偏低,那么可能会给患者带来非常巨大的影响,而长引发红细胞偏低的原因就是贫血,贫血初期对于患的影响并不会太大,但是如果出现红细胞偏低严重情况的话,那么就会引起给中并发症,所以对于红细胞偏低也应重视起来。
红细胞偏低原因
引起红细胞偏低原因非常的多,不管是生活中的磕磕碰碰,还是特殊情况造成的,而医学上被总结为两点,慢性失血以及造血干细胞出现了功能异常等等。
01
慢性失血
在各种慢急性出现问题是引起红细胞偏低的总大可能性之一,而其中慢性失血是最难以发现的,因为其的隐蔽性高,不易被察觉,在很多时候容易被忽略,而其中慢性内出血是最为严重。
这些情况在很多情况下是肉眼无从查起,所以往往需要借助医院检查设备才能将其查出,所以出现红细胞偏低影响常常是头晕,精神低,在红细胞偏低不要急,按照医嘱治疗并不会带来什么困扰。
慢性失血也被称之为,红细胞破坏流失太快,而红细胞生成并没有跟上,也就造成了一度红细胞偏低,对于这种情况是以检查为准的。
02
造血干细胞异常
出现白血病、风湿病等等,都有可能是造血物质出现了一定的缺乏或者是存在着一定的障碍引起的一种身体造血上的疾病,而这种情况多以人体出现红细胞偏低症状性贫血,相对于来说这种情况是较为严重的。
常见红细胞偏低原因为贫血,在医学上这是贫血的一种表现症状,在检查出预防红细胞偏低后果的第一时间会当做贫血来进行调理,而在最后的调理以后,确定了病因才会进行针对性的治疗。

红细胞偏低可能是造血干细胞异常引起
红细胞偏低危害
红细胞偏低可以说是一种不大也不小的病症,因为对于这种病症来说,在正常情况下红细胞偏低危害是不会对女性造成太大的危害,但是如果红细胞偏低一旦严重后将会让患者处于生死边缘,甚至是心脏出现停跳的可能,所以对于红细胞偏低危害也是不得不防的。
01
供氧不足
对于男性女性来说,身体中每一升血液中含有的红细胞数量皆是不一样的,而正是因为这些红细胞,人体才会有足够的氧气供人体消耗,而不会导致缺氧等现象出现,而一旦出现红细胞偏低那么也就将会出现人体供氧不足。
02
机能受到影响
其实很多患者都会有疑问那就是红细胞偏低危害是贫血吗,在医学上大多数红细胞偏低多是贫血造成的,但是要经过确定检查后才能够进行确诊,虽然其它原因引起案例较少,但并不是没有,而贫血常常会引起患者身体出现异常,并可能会因为这些原因,引起其它病症。
03
心脏疾病
红细胞是人体运氧搬运工,一旦出现红细胞偏低那么将会导致心脑等各个器官的供氧不足,如果患者没有及时治疗,久拖将会出现贫血性心脏疾病,在红细胞偏低危害中属于最为严重的情况,到最为严重的时候红细胞偏低危害可能会引起心脏停跳。
在最开始出现贫血症状的时候,可以尝试服用一些含有补充维生素以及营养物质即可,但是如果当引起机体功能、供氧不足甚至是心脏疾病的时候就得加以注意了,防止红细胞偏低危害更加的严重。

红细胞偏低可能会遇到供氧不足、机能影响、心脏疾病等3种危害
红细胞偏低如何治疗
在红细胞偏低治疗中不要心急,因为红细胞偏低在正常情况下来说可能只是属于贫血问题,所以红细胞偏低治疗中并需要太过担心,通常只需要在日常生活中进行调理即可,但是这只是针对并不严重的红细胞偏低治疗,如果过于严重就需要见一定的治疗。
01
补铁药疗
常见红细胞偏低是贫血吗,其实主要原因是缺铁引起的,所以补铁是最常见红细胞偏低怎么办,多以服用药物富马酸铁或者就是硫酸亚铁,通过这些口服药物的作用,能够帮助患者身体快速进行铁元素的补充,病情能够早日康复。
02
食疗
在目前来看红细胞偏低怎么治疗中使用最多的方式就是食疗,因为大多数人都会认为是药三分毒,而采用食疗的方式也是一种不错的选择,通过食物、水果中的维生素以及其它身体所需的营养物质进行补充,如果想要有效缓解红细胞偏低那么可以食用一些动物肝脏。
03
手术治疗
手术治疗通常来说非常少的,针对的人体出现某些慢性失血,内出血等等,在这种情况下只有通过手术的方式才能够进行治愈,但事实相对来说使用这一种方式治疗的人群较少。
在红细胞偏低治疗途中应该定时进行血常规红细胞偏低缓解方法复查,看治疗调理效果是否有效,如治疗效果低下,那么应该在医生的帮助下通过红细胞计数偏低原因再次进行确定,并重新定制针对药物治疗方案进行治疗。
Tips
红细胞偏低治疗如果并不严重的话那么医生只会告诉患回家多吃一点有营养的食物即可,但是如果过于严重,那么医生就会建议患者进行补铁药理、手术治疗,在这种情况下应该配合医生进行治疗,对于药物补铁应该小心铁元素中毒。

在生活中饮食营养均衡是预防红细胞偏低办法之一
孕期红细胞异常
在孕期红细胞偏低医生并不会多加理会,但是如果伴随着红细胞偏低症状,那么就会进行肝病检查、甲亢病症检查,并且是需要治疗的。
孕期调理方式
孕期红细胞偏低并不会对孕妇以及胎儿造成太大的影响,但是如果让红细胞偏低继续发展下去,那么可能将会对肚子里的孩子造成一定的影响,所以为了避免这样的影响孕期红细胞偏低调理是有必要的;对于孕期红细胞偏高危害也是要预防的。
01
食物中摄取铁元素
在孕期检查的时候出现血红蛋白偏低,那就可能就要见红细胞偏低饮食治疗了,那么红细胞偏低吃什么好,其实多以动物内脏、瘦肉、黑木耳以及豆类食物为多,因为他们中含有大量的铁元素。
02
药物补铁
在怀孕的时候很多孕妇的食欲是非常差的,所以采用食疗的方式很多情况下是无法行得通的,所以只有采用要补铁的方式,但是在孕期如乱服药物是一个非常可怕的错误,所以在服用铁之缘片的时候应该真得医生的意见和指导后方可食用。

孕期红细胞偏低可采用食疗补铁的方式进行调理治疗
Tips
孕期中出现红细胞偏低,在治疗方面常使用的方式属于食物铁元素摄取即可,并不需要以服用铁元素药物来进行改善,在孕期红细胞偏低治疗中应保持良好的心态。
试管术中红细胞异常
在试管婴儿众多流程中,在经过长时间的促排后,将会取卵,但在取卵之前会对女性的身体进行检查,其中红细胞检查也是一定的,如果在这个时候红细胞检查出现问题,那么这次的促排将会提前结束,并且要对红细胞异常进行调理,在调理后在进行促排取卵。

促排中红细胞偏低可能会对卵泡已经卵子有一定影响
在试管婴儿促排中应该保持好愉快的心情,这样对于促排的效果或者说对于促排中引起其它不必要的情将会减少,但是一点出现问题就一定要调理后在次进行促排,不然取出的卵子有很大可能将会是问题卵子,配成胚胎的可能性以及胚胎着床率将会出现失败可能性增加。
Tips
红细胞是人体血液中占比最高的一种,如果红细胞出现问题,那么引起血液疾病的可能性也将会非常大,甚至会引起白血病、心脏病以及地中海贫血等疾病,在日常生活中对于各种营养以及维生素的摄取要均衡,这样才能减少红细胞异常几率,对于身体防护更加的好。
以上就是爱之晶给大家介绍的相关内容,如果您还想了解更多的事项可以拨打我们的热线电话,可以点击我们的官网在线实时咨询我们,或者关注我们的官方微信公众号,我们会有专业的工作人员为您解答。
下一篇: 爱之晶海外试管名称解释——促排卵药